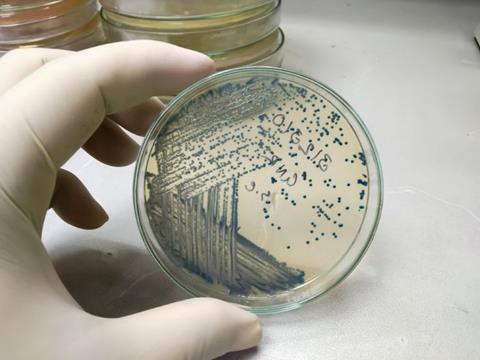
Image

Bioengineered E.coli provide an eco alternative to creating L-DOPA from terephthalic acid, suggests study.
Polyethylene terephthalate (PET) plastic set for landfill could be transformed into L-DOPA, a key medicine for Parkinson’s disease, according to research from the University of Edinburgh.
The innovative study showed that once the plastic is broken down into terephthalic acid, engineered E. coli bacteria can convert the molecules into L-DOPA.
The new technique offers a sustainable approach that helps address the challenge of recycling fossil fuel-based PET, of which current processes are not fully efficient, the team noted.
This project highlights the potential of biology to reshape the way we think about waste. Turning plastic bottles into a Parkinson’s drug isn’t just a creative recycling idea, it’s a way of redesigning processes that work with nature to deliver real-world benefits"
Dr Liz Fletcher, Director of Impact and Deputy CEO at the Industrial Biotechnology Innovation Centre (IBioIC), said: “This project highlights the potential of biology to reshape the way we think about waste. Turning plastic bottles into a Parkinson’s drug isn’t just a creative recycling idea, it’s a way of redesigning processes that work with nature to deliver real-world benefits.
“By demonstrating that a harmful material can be converted into something that improves human health, the team is proving that sustainable, high-value applications of biology are both practical and effective.”
The team plan to further optimise the process and enhance scalability of the technology so it can be advanced towards industrial application.
The research was published in Nature Sustainability.
An earlier promising development in the neurological therapy landscape includes the MHRA last November giving the green light to Eisai and Biogen’s antibody drug Leqembi IV maintenance as an additional treatment option for Alzheimer’s.
More recently, researchers showed it is possible to utilise waste bread as a feedstock for E. coli to generate naturally-produced hydrogen gas. The findings suggest the technique could offer a sustainable alternative for pharmaceutical bioproduction.
Last year also saw an environmentally-friendly innovation that could change how key medicines are produced. In their study, researchers were able to convert agricultural waste, such as rice husks and corncobs, into the medical substances required to produce furosemide, a hypertension treatment.















